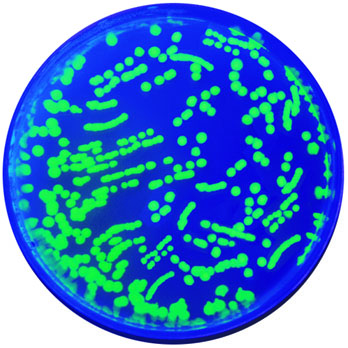

One of the most impactful experiments in the Biotechnology Laboratory is Kit #223, Transformation of E. coli with Green Fluorescent Protein (GFP). We love this experiment for many reasons: green, glowing bacteria, a visual link between genotype and phenotype, and the introduction of real world biotechnology into your classroom. But, we know that teaching and performing the experiment can be challenging! Here is our resource roundup to help you prepare to teach this amazing lesson!
- Edvotek At Home Transformation: We developed this module when schools were mostly virtual; however a lot of the resources within would help you as you get ready to teach this lesson. Simplify your pre-lab preparation by incorporating parts of the included slide presentation into your lecture!
- Blog Post – Five Ways to Improve your Transformation Experiments: While our transformation experiments have been optimized these experiments to be robust and reproducible in your classroom laboratory. This blog post discusses five ways you can ensure your students have experimental success.
- Blog Post – Biotechnology Basics Transformation: A short introduction to transformation and genetic engineering for your students. Just link to this post from your learning management system to give your students a quick overview of the biotechnology!
- YouTube Playlist – Genetic Engineering and Transformation: This playlist features all the relevant Edvotek Video Tutorials in one place, starting with how to pour your plates and ending with fun extensions, (like Colony PCR and Agar Art! (Like these videos? Be sure to subscribe to be alerted when we post new content!)
- Green Fluorescent Protein (GFP), a Nobel Prize Winning Molecule: In this experiment, we are introducing the DNA from a jellyfish into bacteria to make them glow green. This molecule revolutionized molecular biology and biotechnology because of its applications in gene expression, protein localization, purification, and more! Learn more about this molecule in our blog posts “Lighting Up Live with GFP” and “Bright Spot in Science”.
- Blog Post – Biotech Basics Plasmid: Small, circular, extrachromosomal pieces of DNA are used to shuttle DNA between microbes. In this transformation, we use pFluoroGreen to bring the GFP gene into E.coli.
- Blog Post – What is transformation efficiency and why is it important?: In practice, transformation is a highly inefficient process. Transformation efficiency refers to the number of cells transformed per microgram of plasmid DNA. Through teaching your students how to calculate the transformation efficiency, you’ll incorporate quantitation and mathematics into your biotechnology lesson!

1 comment
Comments are closed.